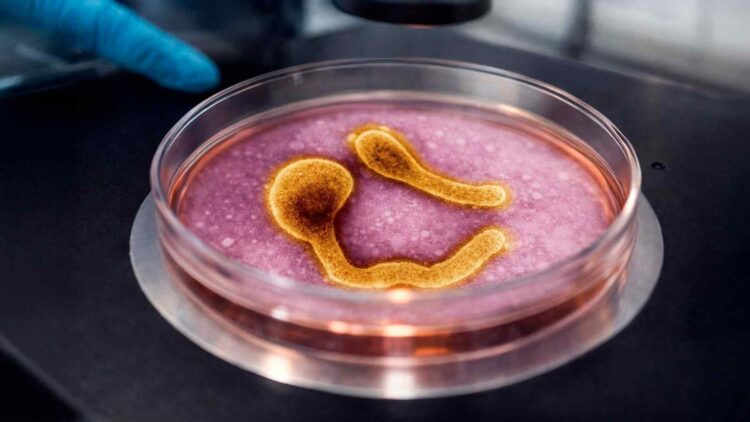
Study explains cholera lethality

A 20-year-old paradox has finally been solved.
Over the last decade, the world has come to better understand how some diseases and infections spread. But a recent discovery has found that bacteria have a paradox that they need to consider. Either they choose survival or become much more lethal to us as humans.
What has led to this remarkable discovery about the decades-long cholera mystery?
How the bacteria of the world spread like wildfire is astonishing
Cholera has been a major health issue for the world.
It kills an estimated 143,000 people worldwide every year. Mostly spread through the consumption of contaminated water and food. Without effective treatment, the fatality rate can be as high as 60%.
However, with fast thinking and action, this can be reduced to less than 1%.
The World Health Organization states that we are currently in the seventh cholera outbreak. It began around 1961 and continues to this day in some parts of the world. But another mystery regarding cholera has taken 20 years to be explained.
How can a disease face a paradoxical choice? The reality is that it will have to choose between survival and its purpose.
Studying the molecular world around us has revealed a few astonishing truths
Human science has expanded into a worldwide effort to better understand how and what we are today.
However, even our progress in human science has not been able to solve this cholera mystery. Despite our bodies’ best efforts, cholera is still a disease that kills thousands every year.
The tiny microscopic world can devastate human life.
We can do our best to avoid catching this fatal disease. But without treatment, cholera continues on its devastating path. Our DNA may enable us to keep the cold at bay, but not this invisible threat from cholera.
Under certain conditions, cholera can spread like wildfire.
We used to believe that water was the major spreader of cholera. But a recent study has found that this may not be the case. Bacteria can spread at an astonishing rate. As noted by the study, “Evolution of pandemic cholera at its global source,” published in Nature.

How a two-decade-long mystery has recently been solved by science
As we are in the seventh global outbreak of cholera, we need to study it extensively.
We have an astonishing capacity in each of our cells. But even our strongest cells would struggle to fight off cholera. The aforementioned study took over 20 years to develop and has recently made its findings public.
Cholera can ravage both humans and animal life around the world. And this study has found that the bacteria have a choice to make deep inside their host.
Cholera bacteria, specifically Vibrio cholerae, have a unique ability to survive the harshest conditions, but at a cost. And the cost affects the bacteria’s ability to spread and cause chaos.
Cholera bacteria have been expanding in certain regions of the world
The study has found that the evolution of cholera bacteria may have led us in the wrong direction.
The loss of specific defense systems in cholera bacteria is directly linked to the severity of the disease. It has been forced to choose between survival and lethality.
So even bacteria face life or death choices.
If the bacteria evolve to maintain these defense systems, their virulence is dramatically reduced. The study noted that cholera bacteria can adapt and choose to survive under the right conditions. But this reduces their severity.
The study proves that the molecular world may have hidden roles and threats. And that we are only now beginning to understand this reality.